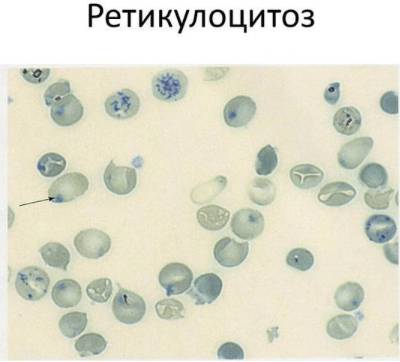

Содержание
Количество ретикулоцитов в крови человека небольшое. Но это очень важный показатель нормального функционирования костного мозга, его способности к регенерации. Ретикулоцитоз в общем анализе крови говорит о том, что в костном мозге по каким-то причинам вырабатывается слишком много эритроцитов.
Роль реткулоцитов
Их формирование начинается в костном мозге и длится до 2 дней. Затем ретикулоциты остаются в крови еще 3 дня и трансформируются в зрелые эритроциты. На созревание ретикулоцитов влияет эритропоэтин (почечный гормон).
Функция ретикулоцитов аналогична эритроцитам, то есть они переносят кислород к тканям. Но они не способны полностью заменить эритроциты.
Присутствие ретикулоцитов в крови свидетельствует о регенеративной способности костного мозга.
Ретикулоцитоз, увеличение уровня ретикулоцитов в крови, вызывает интерес у врачей различных специальностей. По мнению гематологов, этот показатель является важным маркером активности костного мозга и может свидетельствовать о восстановлении после анемии или кровопотери. Однако, как отмечают терапевты, ретикулоцитоз не всегда указывает на положительные процессы; он может быть признаком хронических заболеваний или реакции на воспаление. Важно учитывать клиническую картину в целом, так как изолированный ретикулоцитоз требует дальнейшего обследования для выявления причины. Врачи подчеркивают, что правильная интерпретация результатов анализа и комплексный подход к диагностике играют ключевую роль в лечении пациентов.

Что это такое?
Ретикулоцитоз — это состояние, при котором число назарелых эритроцитов перефирической крови выше нормы (более 1% от общего числа эритроцитов). Это свидетельствует об усиленном образовании красных кровяных телец в костном мозге (напряженный эритропоэз). Другими словами, в кровяное русло выходит большое количество незрелых форм эритроцитов.
Различают два типа ретикулоцитоза: истинный и ложный. При истинном ретикулоциты также повышены в костном мозге. При ложной форме ретикулоциты повышаются только в периферической крови. Это говорит о том, что клетки усиленно вымываются из костного мозга в кровь. Ложный ретикулоцитоз встречается очень часто. У новорожденных детей и у беременных это состояние считается нормой.
Также это может быть реакцией организма на прием некоторых витаминов.

- Сильная кровопотеря (ретикулоцитраный криз). Костный мозг начинает усиленно восполнять недостаток эритроцитов.
- Гемолитическая анемия. При этом заболевании происходит разрушение взрослых эритроцитов, на что костный мозг реагирует повышенным образованием RET.
- Острая гипоксия. Головной мозг не получает достаточно кислорода, поэтому идет усиленная выработка ретикулоцитов, так как они тоже переносят кислород к тканям.
- Внутренне кровотечение (при язве желудка).
- Разрушение эритроцитов (гемолиз) при отравлениях, острых инфекциях, аутоиммунных болезнях.
- Инфекционные заболевания (малярия). Эритроциты разрушаются в селезенке, организм пытается компенсировать потерю производством клеток в костном мозге.
- Опухоль костного мозга. Нарушается функции мозга, раковые клетки раздражают его участки, на что развивается патологическая реакция.
Иногда повышение ретикулоцитов является кратковременным и обратимым.
Оно возникает под воздействием следующих провоцирующих факторов:
- Лечение анемии препаратами железа и витамином В12. Это свидетельствует об эффективности лечения. Показатели нормализуются через неделю после лечения.
- Резкий подъем в высоту. Все приходит в норму через пару дней.
- Беременность. Организм матери нуждается в большем объеме кислорода, а, следовательно, в повышенном количестве эритроцитов.
- Лечение эритропоэтином. Ведь этот гормон стимулирует выработку RET.
- Состояние после трансплантации костного мозга.
- У детей при инфекционных заболеваниях. Так иммунитет ребенка пытается справиться с инфекцией.
- Небольшое повышение может быть у женщины после менструации.
Норма ретикулоцитов
| Возраст | Норма (количество в промилле) |
| Дети до 12 месяцев | От 15 в первый месяц до 2-9 в 12 месяцев. |
| 1-6 лет | 3-11 |
| 7-12 лет | 2-12 |
| 13-16 лет | 2-12 |
| Мужчины | 9-12 |
| Женщины | 2-19 |
Ретикулоцитоз — это состояние, при котором наблюдается повышенное количество ретикулоцитов в крови, что может свидетельствовать о различных заболеваниях или физиологических состояниях. Многие люди, столкнувшиеся с этой проблемой, отмечают, что важно понимать причины повышения уровня этих клеток. Часто это связано с анемией, кровопотерей или восстановлением после хирургических вмешательств. В медицинских кругах активно обсуждаются методы диагностики и лечения, а также значение ретикулоцитов как маркера активности костного мозга. Пациенты делятся опытом, как изменение образа жизни, диета и лечение основного заболевания помогли нормализовать уровень ретикулоцитов. Важно, чтобы каждый, кто сталкивается с этой проблемой, получал квалифицированную помощь и понимал, что ретикулоцитоз — это не просто цифры в анализах, а сигнал организма о необходимости внимания.

Диагностика
Для определения количества ретикулоцитов проводят общий анализ крови.
Этот показатель исследуется не всегда, а при подозрении на патологию.
Исследование назначается при следующих условиях:
- если врач подозревает о наличии внутреннего кровотечения;
- при инфекционных заболеваниях (малярии);
- для отслеживания динамики приживания клеток костного мозга после трансплантации;
- для диагностики анемии;
- при раковых заболеваниях;
- для оценки эффективности терапии препаратами железа;
- при лечении эритропоэтином.

Нормой считается индекс от 2 до 3.
При ретикулоцитозе индекс выше 3.
Особой подготовки к анализу не требуется. Нужно отказаться от приема пищи и напитков за 10 часов до забора крови.
Также за 2-3 дня рекомендуется прекратить прием препаратов, которые стимулируют выработку ретикулоцитов.
Лаборатории используют два метода подсчета клеток:
- Подсчет числа клеток в мазке при окраске их специальным красителем. Это самый простой и быстрый метод, не требующий специального оборудования.
- Метод люминисцентной микроскопии. Для этого кровь смешивают в пробирке с красителем. Данный метод более точен, но для него нужен люминисцентный микроскоп.
Лечение
Ретикулоцитоз не всегда является опасным состоянием. Иногда лечение не требуется, так как повышение показателя является реакцией организма на провоцирующие факторы.
Ситуации, при которых лечение не нужно:
- Беременность до 7 месяцев. В этот период резко увеличивается объем кровотока вследствие развития плода.
- Небольшие кровопотери. Организм сам восполнит дефицит эритроцитов за несколько дней.
- Терапия анемии. Ретикулоцитоз свидетельствует об успешности терапии, после излечения показатели нормализуются.
- Физиологический гемолиз (разрушение эритроцитов вследствие инфекции, приема лекарств). Нужно лишь скорректировать дозировку препаратов. После того, как инфекция пройдет, количество ретикулоцитов снизится.
Терапия нужна в случаях патологического гемолиза (при серьезных отравлениях), сильной кровопотере, нарушении процесса кроветворения в костном мозге.
Лечение зависит от первопричины патологического состояния. Применяют следующие виды терапии:
- Если причина повышения RET кроется в острой кровопотере, то больному требуется переливание плазмы или цельной крови.
- При отравлениях пациенту назначается инфузионная терапия в условиях реанимации.
- Плазмаферез делают при чрезмерных аутоиммунных реакциях.
- В случае обнаружения опухоли или метастазов больному проводится химиотерапия или хирургическое удаление новообразования.

Последствия
Патологическое и длительное увеличение числа ретикулоцитов представляет серьезную опасность для организма. Происходит повышение вязкости крови, мелкие сосуды склерозируются.
Поэтому возрастает риск сердечно-сосудистых заболеваний, тромбозов.
Отсюда вытекают следующие осложнения:
- тромбоэмболия;
- инфаркт;
- инсульт;
- некроз тканей рук и ног.
Прогноз и профилактика

Профилактика ретикулоцитоза заключается в соблюдении следующих условий:
- избегании потери крови и контакта с ядовитыми веществами;
- лечении инфекционных заболеваний;
- приеме витаминов для предупреждения анемии;
- своевременном обследовании крови.
Ретикулоцитоз показывает, что с организмом пациента не все в порядке.
Отклонение показателей крови от нормы нельзя игнорировать. Следует установить причину и определиться с тактикой лечения. Однако, не стоит паниковать, если обнаружено повышение RET. Во многих случаях состояние является физиологически и обратимым без специального лечения.
Вопрос-ответ
Что такое ретикулоцитоз и как он определяется?
Ретикулоцитоз — это состояние, характеризующееся повышенным уровнем ретикулоцитов в крови, которые являются незрелыми эритроцитами. Он определяется с помощью общего анализа крови, где измеряется количество ретикулоцитов в процентном соотношении к общему числу эритроцитов или в абсолютных значениях на литр крови.
Какие причины могут вызывать ретикулоцитоз?
Ретикулоцитоз может быть вызван различными факторами, включая анемию, кровотечения, гемолиз (разрушение эритроцитов), а также реакции на лечение, например, после переливания крови. Он также может наблюдаться при восстановлении после дефицита железа или витаминов.
Каковы симптомы и последствия ретикулоцитоза?
Симптомы ретикулоцитоза могут варьироваться в зависимости от основной причины. Часто это может быть связано с симптомами анемии, такими как усталость, слабость и одышка. Важно выявить и лечить основное заболевание, так как игнорирование состояния может привести к серьезным осложнениям, включая ухудшение общего состояния здоровья.
Советы
СОВЕТ №1
Обратите внимание на симптомы. Ретикулоцитоз может быть признаком различных заболеваний, поэтому важно следить за такими симптомами, как усталость, головокружение или бледность кожи. Если вы заметили их, обратитесь к врачу для дальнейшего обследования.
СОВЕТ №2
Регулярно проходите медицинские обследования. Анализы крови помогут выявить уровень ретикулоцитов и другие показатели, что позволит своевременно диагностировать возможные проблемы с кроветворением.
СОВЕТ №3
Обратите внимание на свой рацион. Убедитесь, что ваше питание богато железом, витаминами B12 и фолиевой кислотой, так как они играют ключевую роль в производстве красных кровяных клеток и могут помочь в нормализации уровня ретикулоцитов.
СОВЕТ №4
Не игнорируйте рекомендации врача. Если вам назначили лечение или дополнительные исследования, следуйте указаниям специалиста, чтобы избежать осложнений и улучшить свое состояние.

